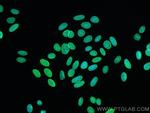
Lamin A/C Antibody in Immunocytochemistry (ICC/IF)

Search
Proteintech
Lamin A/C Recombinant Rabbit Monoclonal Antibody (5I16)
{{$productOrderCtrl.translations['antibody.pdp.commerceCard.promotion.promotions']}}
{{$productOrderCtrl.translations['antibody.pdp.commerceCard.promotion.viewpromo']}}
{{$productOrderCtrl.translations['antibody.pdp.commerceCard.promotion.promocode']}}: {{promo.promoCode}} {{promo.promoTitle}} {{promo.promoDescription}}. {{$productOrderCtrl.translations['antibody.pdp.commerceCard.promotion.learnmore']}}
产品信息
81042-1-RR100UL
种属反应
宿主/亚型
Expression System
分类
类型
克隆号
偶联物
形式
浓度
规格
纯化类型
保存液
内含物
保存条件
运输条件
靶标信息
Lamins are a class of intermediate filament proteins that form a matrix on the inner surface of the nuclear envelope. These proteins are found in many different cell types in three different forms (A, B, and C). Lamins A and C are alternatively spliced versions of the LMNA gene. The LMNA gene has been linked to many disorders of the muscular system, nervous system, and the fat distributions systems including: Emery-Dreifuss muscular dystrophy, Dunnigan-type familial partial lipodystrophy (FPLD), limb-girdle muscular dystrophy (LGMD1B), dilated cardiomyopathy (CMD1A), axonal neuropathy (Charcot-Marie-Tooth disease; CMT2B1), and mandibuloacral dysplasia (MAD).
仅用于科研。不用于诊断过程。未经明确授权不得转售。
篇参考文献 (0)
生物信息学
蛋白别名: 70 kDa lamin; epididymis secretory sperm binding protein; lamin A protein; Lamin A+C mutant; lamin a-c; lamin A/C; lamin A/C-like 1; Lamin AC; lamin C; lamin C protein; mandibuloacral dysplasia type A; mutant 453W; Mutant lamin A/C; Prelamin-A/C; progerin; progerin mutant; renal carcinoma antigen NY-REN-32; RP11-54H19.1; unnamed protein product
基因别名: CDCD1; CDDC; CMD1A; CMT2B1; EMD2; FPL; FPLD; FPLD2; HGPS; IDC; LDP1; LFP; LGMD1B; LMN1; LMNA; LMNC; LMNL1; MADA; PRO1
UniProt ID: (Human) P02545
Entrez Gene ID: (Human) 4000